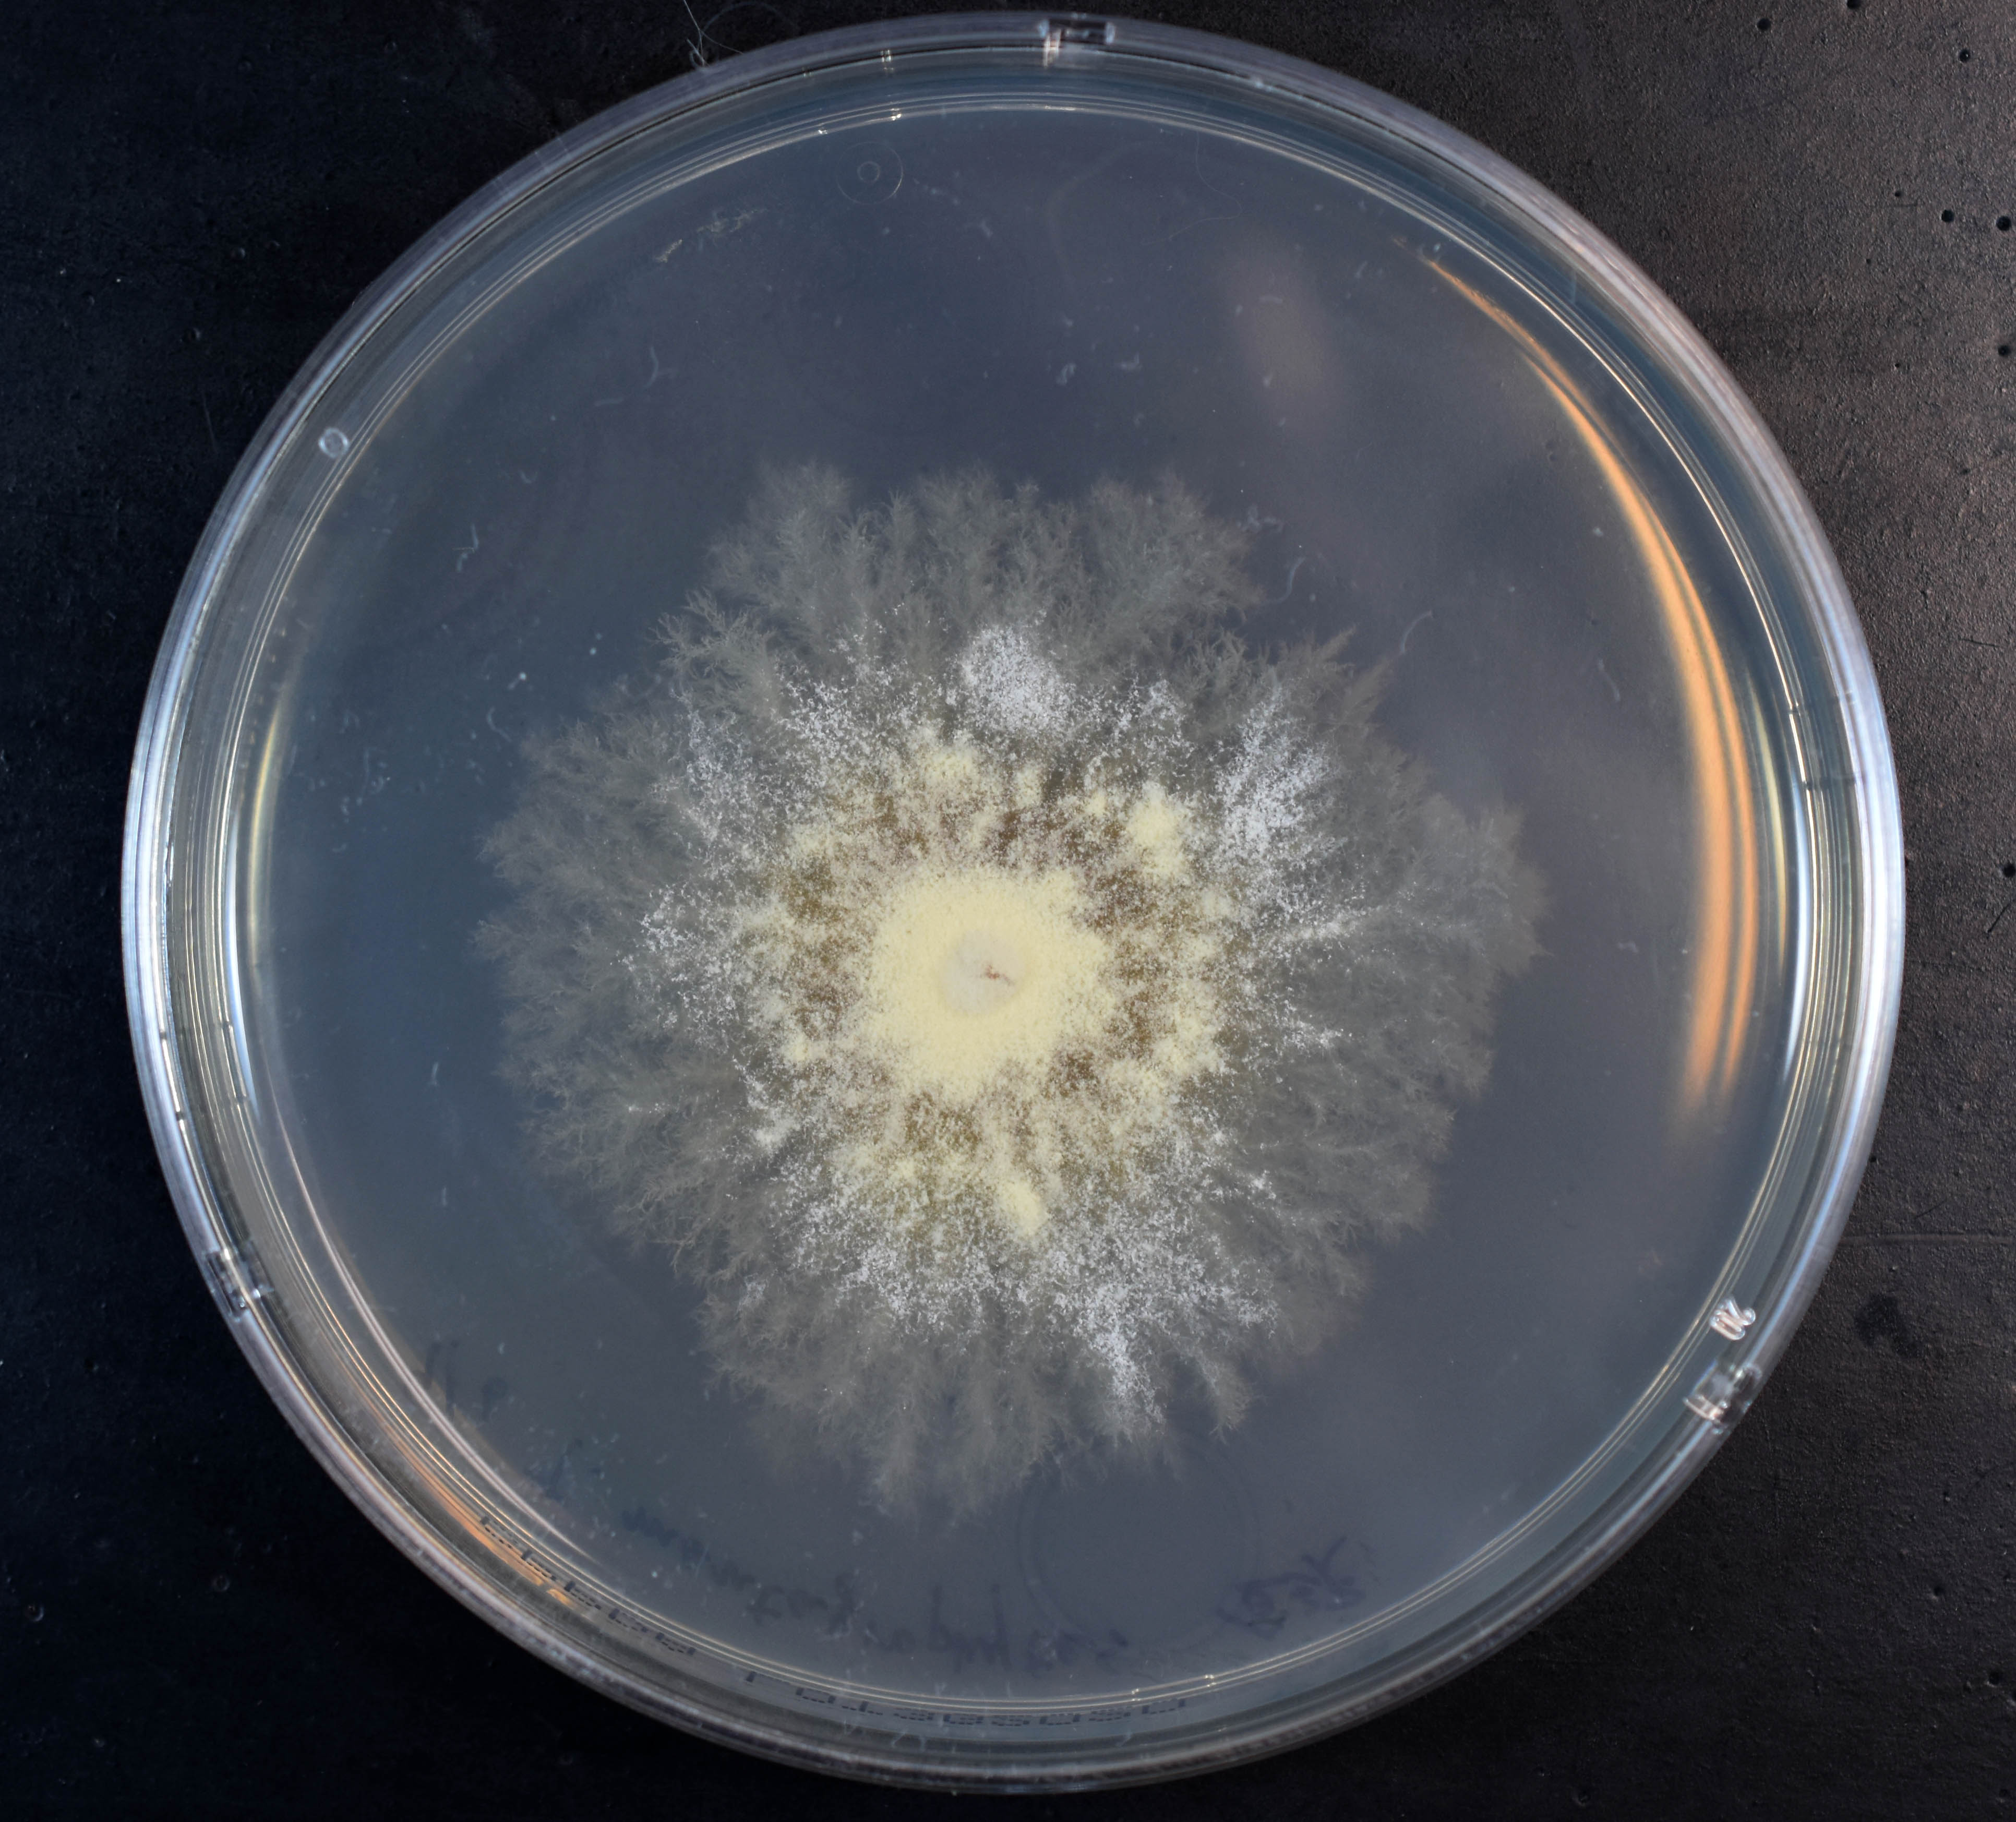
槇村 浩一 Prof Koichi Makimura Md Phd トリコフィトン インテルジギターレ かつての名前であったトリコフィトン メンタグロフィテスt Mentagrophytes 毛瘡菌 は今や別種 たまには巨大培養像 黄色調の粉っぽい集落表面をお楽しみ下さい

√ダウンロード トリコフィトン画像 182197
常在真菌アレルギー 常在真菌は人の体に常在する真菌です。 マラセチアは、アトピー性皮膚炎の悪化因子のひとつとして報告されています 1),2) 。 また、トリコフィトンは白癬菌(はくせんきん)の主な原因真菌と知られ、ぜん息の悪化因子のひとつとして報告されています 2) 。(トリコフィトン・トンズランス感染症) 広島皮膚科医会 篠田 勧、山本 匡 はじめに 01 年、高校生や中学生の格闘技競技者(柔道部やレスリング部)にトリコフィトン・ トンズランス(以下トンズランス)菌の集団感染が報告されました。トリコフィトン・トンズランス( Trichophyton tonsurans )は、白癬の一種。 培養日数の経過につれ、菌株が噴火口状(crateriform)に陥没する場合もあるため、 トリコフィトン・クラテリフォルメ ( Trichophyton crateriforme ) 1 と呼称されることもあった 2 3 。

トリコフィトン 白癬菌 はくせんきん アレルギー 花粉症クエスト アレルギー辞典 花粉症の最新予防 対策なら 花粉症クエスト
トリコフィトン画像
トリコフィトン画像-ひげ白癬(白癬性毛瘡)は、一般にひげが生える部位(須毛部)に起こる皮膚糸状菌(真菌)感染症です。 ( 皮膚真菌感染症の概要 皮膚真菌感染症の概要 真菌は通常、足の指の間、性器の周辺、乳房の下など、体の皮膚同士が触れ合っていて、湿度が日本産糸状菌類図鑑の索引。例えば、Alternaria alternata、Alternaria alternata Keiss、Alternaria alternata (Fr) Keiss、Alternaria panax、Alternaria panax Whetzel apud Whetzel &




19 号 白癬菌の遺伝子をlamp法により検出するためのプライマーセット及びそれを含むキット並びにそれらを用いて白癬菌を検出する方法 Astamuse
トリコフィトン・メンタグロフィテス(毛瘡白癬菌) Trichophyton mentagrophytes 皮膚糸状菌症(白癬)の原因になる皮膚糸状菌は、ヒトや動物の皮膚、毛髪、爪などに主成分として含まれているケラチンとよばれる不溶性タンパク質を分解して栄養源にする能力を持つ。「柔道選手のトリコフィトン・トンスランス感染症」知っておこう! ~その治療と予防法~ 01年より全国の柔道やレスリング選手を中心にTrichophyton tonsurans(トリコフィトン・トンスランス)という皮膚真菌症<タムシ>の感染例が増加しています。トリコフィトントンズランスなのか、 それ以外の白癬菌か判断できます。し かし、本感染症では注意深く観察しな いと皮疹を確認することが困難な例も 多く、皮膚科専門医でも誤診してしま うことが多いです。 特に、無症候性キャリアの診断には
新型水虫、トリコフィトン・トンズランスとは? もともと日本には存在しない水虫菌だったのですが、1950年代にメキシコ、プエルトリコなどの中南米で発見され、1960年代にはアメリカ、そして01年に 格闘技での海外との交流 によって日本に上陸しました「トリコフィトン・トンズランス感染症」 さてさて、どれにも当てはまりそうな・・・・ そこで、その相談者の現在の生活についてヒアリングしてみた。 qいつ頃からでき始めたのか? a2週間前くらいから qその時期に生活の中で何か変化はあったのか?岩崎信広:(講演)画像診断におけるusの役割必要な知識と考え方 第179回 大阪腹部超音波研究会, 21 松下隆史、栃尾人司、杉之下与志樹、他:急性胆嚢炎を契機に腹部USで発見し得た胆嚢癌~Mixed Adeno NeuroEndcrineCarcinomas(MANECs)の一例~本超音波医学会第41回関西地方会学術集会,京都,
トリコフィトン・トンスランスの多くは、体部や頭 部に感染します。だからこそ、体が直接接触する格闘 技で感染が広がりやすいのです。またかゆみなどの症 状が現れにくいため、治療に至らず感染が拡大してし まうというのが現状です。Q2 皮膚糸状菌(白癬菌)とは何ですか? 皮膚糸状菌(白癬菌)というカビは、その形態から白癬菌属、小胞子菌属、表皮菌属に分類されています。 白癬を起こす皮膚糸状菌は世界には40種類以上存在しますが、日本ではこのうちの10種類ほどがヒトに白癬白癬菌(Trichophyton) 白癬菌は黄癬菌らと共に皮膚糸状菌と呼ばれる菌種に属し、これらは、ケラチン消化能をもち、髪、爪及び表皮の構造タンパク質であるケラチンを消化するケラチナーゼ を産生する。 白癬(水虫)には、趾間 (シカン)型、水疱型



Derma Okayama Net




真菌と抗真菌剤
Rosenb、Alternaria solani、Alternaria solani Sorauer、Alternaria solani (Ellis &円 シャトー ムートン ロートシルト 17 750ml ビール・洋酒 ワイン 赤ワインTrichophyton spp トリコフィトン 皮膚糸状菌症をおこす真菌の一属で,皮膚,毛髪,爪に感染する. 系統 抗菌薬 感受性 標準菌株 標準菌のMIC 臨床分離菌のMIC80 臨床分離菌のMIC60




トリコフィトンの意味 用法を知る Astamuse



Yakult Co Jp
日本大百科全書(ニッポニカ) 白癬菌の用語解説 細長い糸の形状をした皮膚糸状菌に分類される真菌(カビ)の一属。トリコフィトンTrichophyton。皮膚糸状菌には、白癬菌のほかに小胞子菌属、表皮菌属もあるが、これらは同義として扱われることもある。Martin) Sorauer、Arthrinum KuntzeFr、Arthrinum st、などの用語があります。それが、トリコフィトン・トンズランス感染症 画像や症状などを見て驚いた。 これ、、、、、 25才から大人アトピーとか診断されてきた俺と同じやん とね。 そう、私はたぶん、ずっと「トリコフィトン・トンズランス感染症」だったと思われる。




Category Trichophyton Tonsurans Wikimedia Commons




Jpa Method Of Treatment Google Patents
しかし「日本人は10人に1人は爪水虫」と調査結果も出ているので、画像を見て改めて自分が爪水虫かもしれないと思い始める方も多いです。 女性の場合は、サンダルを履いたりペディキュアを塗ったりと、足の先まで美意識が高いので「 女性のが自覚症状がある 」でしょう。真菌・放線菌ギャラリーの画像の二次利用を希望される際は、事前に千葉大学真菌医学研究センター バイオリソース管理室にお問い合わせいただけますと幸いです。 colony / トリコフィトン・メンタグロフィテス(コロニー)Created Date 12/2/13 PM




槇村 浩一 Prof Koichi Makimura Md Phd トリコフィトン ルブルムのポテトデキストロース寒天培地も Pda 上の巨大培養像 左 表面 右 裏面 ルブルムはラテン語で赤なので 赤いトリコフィトンだけれども サブローデキストロース寒天培地 Sda



特表18 知財ポータル Ip Force




足だけではない 感染力強い水虫の菌が頭や体に Nikkei Style




プラズマクラスター技術で白癬菌の抑制効果を実証 シャープ




Jpa Method Of Treatment Google Patents



1



しらくも




トリコフィトン属 僕が細菌学者になるまで




Jpa Method Of Treatment Google Patents




今度は水虫 シャープ プラズマクラスターの新効果 産経ニュース



Sports Hc Keio Ac Jp



Appsv Main Teikyo U Ac Jp



Derma Okayama Net




プラズマクラスター技術が水虫菌に抑制効果を発揮することを実証 プラズマクラスター技術 シャープ




表皮植物症の病原体 症状 診断 治療



ミズムシ 筏バンド




プラズマクラスター技術が水虫菌に抑制効果を発揮することを実証 ニュースリリース シャープ




水虫 爪水虫治療 治療薬 通販ナビ 水虫菌 白癬菌 とは




1994 号 皮膚糸状菌症用ワクチン Astamuse




Jpa トリコフィトン trichophyton 属菌を検出するための核酸断片及びそれを用いたトリコフィトン trichophyton 属菌の検出方法 Google Patents




外来物新種の水虫があなたの周囲に出没 徐々にあなたの皮膚を蝕んでいく 真実は何処にあるのブログ




プラズマクラスター技術が水虫菌に抑制効果を発揮することを実証 プラズマクラスター技術 シャープ



検査室タイムズ Tekari 臨床検査技術部




白癬菌真菌違い Chisoku




水虫治療 不潔恐怖とトリコフィトンの秘密 仙人さんの教え 実践したら人生変わった




柔道などの競技者で集団感染も トリコフィトン トンスランス感染症 Schoowell スクウェル




槇村 浩一 Prof Koichi Makimura Md Phd トリコフィトン エクイヌムのポテトデキストロース寒天培地上27 24日デジタル顕微鏡0倍像 お トリコフィトン トンスランス と似たマッチ棒状の分生子が見える が 小さい T Co Phj7xex0nu




Ljjgweu0bn Qmm




格闘技選手に新型水虫 ヨミドクター 読売新聞



Judo Gifu Sakura Ne Jp



診療案内 Yamazaki Dental Clinic



日本臨床皮膚科医会 ひふの病気




シャープのプラズマクラスターイオンで 水虫菌の抑制効果 を実証 n R



Trichophyton Mentagrophytes Micro




トリコフィトンベルコサム




日本でも数万人が感染 頭が禿げる新型水虫 トリコフィトン トンズランス菌 の恐怖 Ash のブログ 答えは聞かないけどっ みんカラ



Derma Okayama Net




カビ対策マニュアル 基礎編 文部科学省




ルシアンヤフーショッピング店 白癬菌は家庭で広がる 感染症最新ニュースとコラム Yahoo ショッピング




19 号 白癬菌の遺伝子をlamp法により検出するためのプライマーセット及びそれを含むキット並びにそれらを用いて白癬菌を検出する方法 Astamuse




Fungi And Actinomycetes Gallery Chiba University Academic Resource Collections C Arc
_From_a_microculture_and_an_infected_hair.jpg/440px-Trichophyton_mentagrophytes_(257_19)_From_a_microculture_and_an_infected_hair.jpg)



トリコフィトンインターデジタル




O Xrhsths 醸して学ぶbot Sto Twitter T ルブラム 白癬菌 体表感染菌 体表を好む皮膚糸状菌 要するに水虫菌 これらが取り付くと 水虫たむしになる 足白癬だけでなく爪白癬の原因にもなるので気を付けましょう T Co Rlfat1drnl Twitter




シャープ プラズマクラスター技術が水虫菌に抑制効果を発揮することを実証 家電 Watch




新型水虫トリコフィトントンズランス 公式 敦賀市で漢方薬 処方箋 健康サポート関連商品はツルガ薬局へ

槇村 浩一 Prof Koichi Makimura Md Phd トリコフィトン インテルジギターレ かつての名前であったトリコフィトン メンタグロフィテスt Mentagrophytes 毛瘡菌 は今や別種 たまには巨大培養像 黄色調の粉っぽい集落表面をお楽しみ下さい



トリコフィトン トンズランス真菌 オレア



これって アレルギー Is It Allergy 喘息 アレルギー リウマチ 花粉症疾患情報 喘息 小児喘息 咳喘息 アレルギー 花粉症 リウマチ の専門 新橋アレルギー リウマチ クリニック



Fcho Jp




5309号 ポリマー及びテルビナフィンから形成されるナノ粒子 Astamuse




格闘技選手の たむし 岡田整形外科 Okada Orthopedic Surgery




新 真菌シリーズ 4月号 栄研化学




商品詳細ページ メディカルブックセンター




カビ対策の決定版 カビ博士 のおもしろカビ講座 特集記事 元気通信 養命酒製造株式会社




日本でも数万人が感染 頭が禿げる新型水虫 トリコフィトン トンズランス菌 の恐怖 Ash のブログ 答えは聞かないけどっ みんカラ



Yakult Co Jp




真菌 放線菌ギャラリー 千葉大学学術リソースコレクション C Arc




プラズマクラスター技術で白癬菌の抑制効果を実証 シャープ



1



Kyorin Pharm Co Jp




真菌 放線菌ギャラリー 千葉大学学術リソースコレクション C Arc




症例から学ぶ トリコフィトンの職業性曝露が増悪の原因と考えられた咳喘息の一例 M Review



Luconac Spline



第87話 はくせんって何 まず敵を知る必要が ありまぁす 有限会社シェパード中央家畜診療所




トリコフィトン 白癬菌 はくせんきん アレルギー 花粉症クエスト アレルギー辞典 花粉症の最新予防 対策なら 花粉症クエスト



白癬菌 Trichophyton Rubrum




カビ対策の決定版 カビ博士 のおもしろカビ講座 特集記事 元気通信 養命酒製造株式会社



ミズムシ 筏バンド




トリコフィトン




トリコフィトントンズランスの恐怖 Toward The Future




年ぶり 抗真菌爪白癬治療薬 ネイリン カプセル が 製造販売承認を取得 好奇心の扉



約二ヶ月前 おでこに湿疹が現れました 最初は10円玉ぐらいの大きさ Yahoo 知恵袋



Derma Okayama Net




柔道などの競技者で集団感染もトリコフィトン トンスランス感染症 順天堂大学大学院スポーツ健康科学研究科 広瀬伸良教授 医療ニュース トピックス 時事メディカル 時事通信の医療ニュースサイト



Sports Hc Keio Ac Jp



診療案内 Yamazaki Dental Clinic




トリコフィトーシス Trichophytosis トリコフィトン Trichophyton の原因物質は



1



Fcho Jp




盗賊 文字通り インポート トンズランス Smileship Jp



第86話 はくせんって何 近寄らないで うつるから 有限会社シェパード中央家畜診療所




あき皮ふ科 トリコフィトン トンズランス感染症 柔道選手やレスリング選手のいわゆる たむし Facebook




トリコフィトン トンズランス Wikipedia




トリコフィトン 白癬菌 はくせんきん アレルギー 花粉症クエスト アレルギー辞典 花粉症の最新予防 対策なら 花粉症クエスト




水虫菌 うさぎもち日和 桜前線のつづき




トリコフィトンの意味 用法を知る Astamuse




トリコフィトンの意味 用法を知る Astamuse




顔 頭皮に 新型水虫 トンズランス菌 への感染予防策 水虫 情報館



うつっちゃったーっっっ 白癬のお話 有限会社シェパード中央家畜診療所




白癬 水虫 の原因となる白癬菌の種類と治療法 メディカルノート



診療案内 Yamazaki Dental Clinic




真菌 放線菌ギャラリー 千葉大学学術リソースコレクション C Arc




カビ対策の決定版 カビ博士 のおもしろカビ講座 特集記事 元気通信 養命酒製造株式会社




トリコフィトン トンズランス感染症 水虫専科



Derma Okayama Net




号 生存菌類寄生微生物ピシウム オリガンドラムを含む 皮膚および粘膜の皮膚糸状菌症および酵母感染症の処置用製剤 微生物ピシウム オリガンドラムの細胞生存率を決定する方法ならびに該製剤の適用方法 Astamuse




トンスランス感染症の予防 全日本柔道連盟




槇村 浩一 Prof Koichi Makimura Md Phd 年第37菌曜日 担子菌酵母 トリコスポロン アサヒイ Trichosporon Asahii 白癬菌のトリコフィトンtrichophytonと字面が似ていて 混同することがある 明治薬科大学の杉田隆教授の再分類が有名




コメント
コメントを投稿